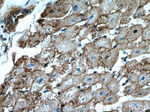
ATP1A2 Antibody in Immunohistochemistry (Paraffin) (IHC (P))

Search
Proteintech
ATP1A2 Polyclonal Antibody
{{$productOrderCtrl.translations['antibody.pdp.commerceCard.promotion.promotions']}}
{{$productOrderCtrl.translations['antibody.pdp.commerceCard.promotion.viewpromo']}}
{{$productOrderCtrl.translations['antibody.pdp.commerceCard.promotion.promocode']}}: {{promo.promoCode}} {{promo.promoTitle}} {{promo.promoDescription}}. {{$productOrderCtrl.translations['antibody.pdp.commerceCard.promotion.learnmore']}}
产品信息
16836-1-AP
种属反应
已发表种属
宿主/亚型
分类
类型
抗原
偶联物
形式
浓度
规格
纯化类型
保存液
内含物
保存条件
运输条件
产品详细信息
This antibody was raised against the internal region of the human ATP1A2 and can recognize all the isoforms of alpha subunit. The 65 kDa band detected occasionally may be the degradation product of ATP1A2.
Immunogen sequence: KRMARKNCL VKNLEAVETL GSTSTICSDK TGTLTQNRMT VAHMWFDNQI HEADTTEDQS GATFDKRSPT WTALSRIAGL CNRAVFKAGQ ENISVSKRDT AGDASESALL KCIELSCGSV RKMRDRNPKV AEIPFNSTNK YQLSIHERED SPQSHVLVMK GAPERILDRC STILVQGKEI PLDKEMQDAF QNAYMELGGL GERVLGFCQL NLPSGKFPRG FKFDTDELNF PTEKLCFVGL MSMIDPPRAA VPDAVGKCRS AGIKVIMVTG DHPITAKAIA KGVGIISEGN ETVEDIAARL NIPMSQVNPR EAKACVVHGS DLKDMTSEQL DEILKNHTEI VFARTSPQQK LIIVE (347-700 aa encoded by BC052271)
靶标信息
Atp1a2 encodes an Na+/K+ ATPase, which is a membrane protein that is composed of two subunits - alpha and beta. The Na+/K+ ATPase pump maintains an essential electrochemical gradient within cells through the active transport of sodium (Na+) and potassium (K+) ions. The Atp1a2 encoded protein belongs to the family of P-type cation transport ATPases, and to the subfamily of Na+/K+ -ATPases. Na+/K+ -ATPase is an integral membrane protein responsible for establishing and maintaining the electrochemical gradients of Na and K ions across the plasma membrane. These ion gradients are essential for osmoregulation, for sodium-coupled transport of a variety of organic and inorganic molecules, and for electrical excitability of nerve and muscle. The ATPase enzyme is composed of two subunits, a large catalytic subunit (alpha) and a smaller glycoprotein subunit (beta), and the catalytic subunit of Na+/K+ -ATPase is encoded by multiple genes. The Atp1a2 gene encodes an alpha 2 subunit. Mutations in the Atp1a2 gene result in familial basilar or hemiplegic migraines, and in a rare syndrome known as alternating hemiplegia of childhood. Diseases associated with ATP1A2 include Alternating Hemiplegia Of Childhood and Migraine, Familial Hemiplegic, 2.
仅用于科研。不用于诊断过程。未经明确授权不得转售。
生物信息学
蛋白别名: ATPase Na+/K+ transporting alpha 2 polypeptide; ATPase, Na+K+ transporting, alpha 2; Na(+)/K(+) ATPase alpha(+) subunit; Na(+)/K(+) ATPase alpha-2 subunit; Na+/K+ -ATPase alpha 2 subunit; Na+/K+ ATPase, alpha-A(+) catalytic polypeptide; Na+/K+ ATPase, alpha-B polypeptide; Na,K-ATPase subunit alpha-B; Sodium Potassium ATPase; Sodium pump subunit alpha-2; sodium-potassium ATPase catalytic subunit alpha-2; sodium/potassium-transporting ATPase alpha-2 chain; Sodium/potassium-transporting ATPase subunit alpha-2; unnamed protein product
基因别名: ATP1A2; Atpa-3; AW060654; DEE98; FARIMPD; FHM2; KIAA0778; MHP2; mKIAA0778; RATATPA2
UniProt ID: (Human) P50993, (Rat) P06686, (Mouse) Q6PIE5
Entrez Gene ID: (Human) 477, (Rat) 24212, (Mouse) 98660